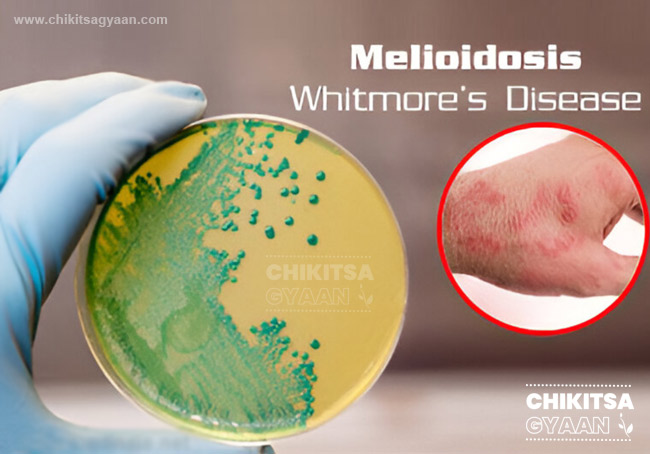
Melioidosis – The Emerging Threat in India

Why Autism is Called ASD (Autism Spectrum Disorder)
Autism, also known as Autism Spectrum Disorder (ASD), is a neurodevelopmental condition that affects how a child communicates, interact...
Ectopic Pregnancy Symptoms, Causes and Warning Signs
An ectopic pregnancy is a serious condition in which a fertilized egg implants outside the uterus, rather than inside it.
In a normal ...
H3N2 Flu Symptoms, Prevention and Current Situation in India
Understanding H3N2 Flu – Symptoms, Prevention & Current Situation in India
As the seasons change, flu-like illnesses tend to sprea...
Healthy and Balanced Life: Tips for Physical and Mental Wellness
Physical health is the cornerstone of overall well-being. It goes beyond just being free from illness—it means having the energy, stren...
Human Anatomy: Structure and Functions of the Human Body
Human anatomy is the scientific study of the structure of the human body. It forms the foundation of medicine, healthcare, and biology,...
Human Physiology: Functions and Science of the Human Body
Physiology is the branch of biology that studies the functions and mechanisms of the human body. While anatomy tells us about the struc...
Melioidosis – The Emerging Threat in India
Melioidosis, also known as Whitmore’s Disease, is a dangerous infectious illness caused by the bacterium Burkholderia pseudomallei, fou...
Speech Delay Therapy for Children: Benefits and Early Support
Speech and language development is one of the most important aspects of a child’s overall growth. Every child follows certain developme...
What is ADHD? Attention Deficit Hyperactivity Disorder
ADHD (Attention Deficit Hyperactivity Disorder) is not a disease, but a developmental condition that affects behavior, focus, and self-...
What is Urticaria? Causes, Symptoms, Prevention, and Home Remedies
Sometimes, our skin suddenly develops red, raised, itchy welts or rashes that can be quite irritating. This condition is commonly known...
Our Latest Posts
A Woman’s Period Journey: Understanding Menarche, Menstrual Health & Menopause
The menstrual cycle is one of the most important milestones in a woman's life. From the first period during adolescence to the natural ...
Digital Detox: A Step Towards a Healthier and Happier Life
In today's fast-paced digital world, we are more connected than ever before. Yet despite constant connectivity, many people feel stress...
Insulin: The Hormone That Controls Blood Sugar, Weight & Metabolism
Insulin is one of the most important hormones in the human body. Produced by the pancreas, it acts as a key that allows glucose (sugar)...
Life-Saving Hormones: How Estrogen, Adrenaline & Insulin Protect Your Body
Our body is an incredible biological system powered by hormones that work silently behind the scenes every second of the day. Among the...
Jalandhara Bandha (Chin Lock)
Yoga is far more than physical exercise—it is a powerful science of balancing the body’s internal energy. Among the many advanced yogic...
Oral-Motor Skills in Autistic Children: Why Eating and Speaking Can Be Challenging
Children with autism often face unique developmental challenges, and among the most common are difficulties related to eating, chewing,...
5 Powerful Flowers That Can Revive Your Hair Naturally
In today’s fast-paced world, pollution, stress, unhealthy lifestyles, and chemical-based hair products are damaging our hair more than ...
What is Urticaria? Causes, Symptoms, Prevention, and Home Remedies
Sometimes, our skin suddenly develops red, raised, itchy welts or rashes that can be quite irritating. This condition is commonly known...
What is ADHD? Attention Deficit Hyperactivity Disorder
ADHD (Attention Deficit Hyperactivity Disorder) is not a disease, but a developmental condition that affects behavior, focus, and self-...
Speech Delay Therapy for Children: Benefits and Early Support
Speech and language development is one of the most important aspects of a child’s overall growth. Every child follows certain developme...
Melioidosis – The Emerging Threat in India
Melioidosis, also known as Whitmore’s Disease, is a dangerous infectious illness caused by the bacterium Burkholderia pseudomallei, fou...
Does Your Child Have a Whistling Sound While Breathing? It Could be Bronchiolitis
Colds and coughs are very common in children during the winter season. However, what looks like a simple cold can sometimes turn into a...
Early Signs of Alzheimer’s Disease and Memory Loss Symptoms
Alzheimer’s disease is a progressive neurological disorder in which brain cells gradually die, leading to memory loss, difficulty in th...
What Is Bhu-Amla? How It Supports Overall Health Naturally
Bhu-Amla, also known as Bhui Amla or Bhumimalaki, is a powerful medicinal plant widely used in Ayurveda and traditional Indian medicine...
Food Sensitivities in Autism: Gut Health and Behavior Explained
Picky eating is more than just disliking certain foods — especially in children with autism. These children may reject foods due to col...